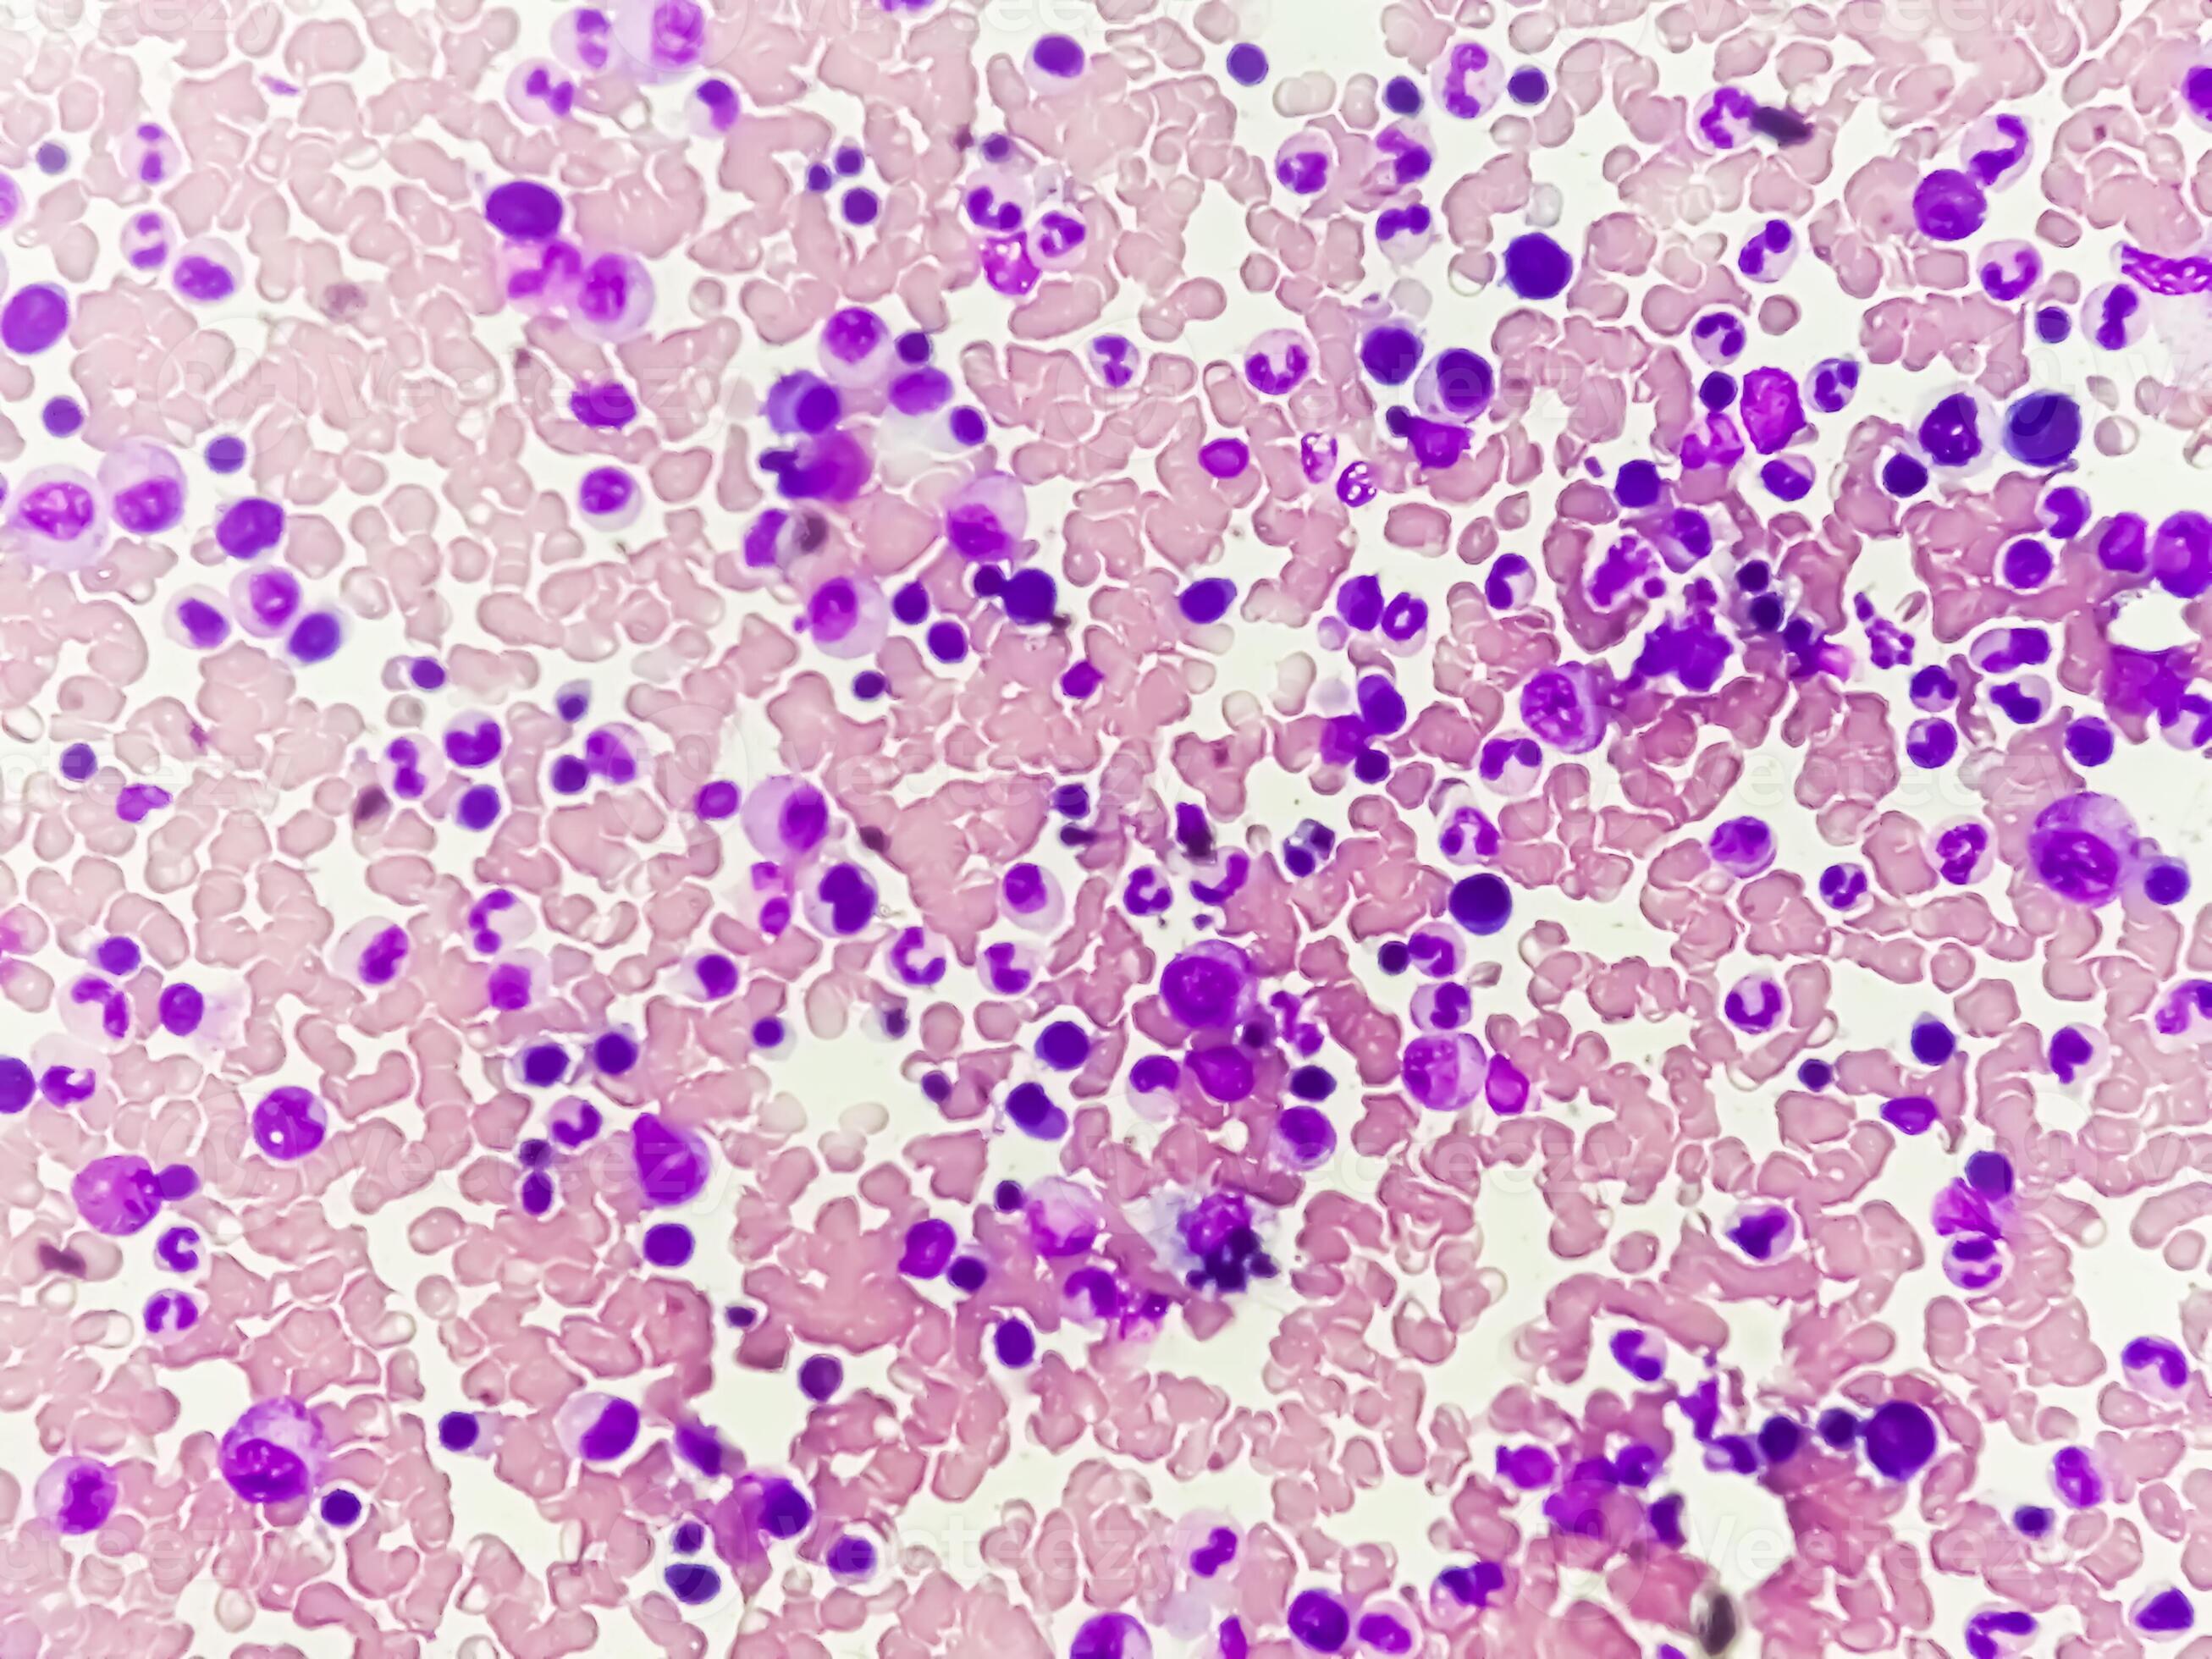

Microsoft support is here to help you with microsoft products. Learn how to install, reinstall, or activate microsoft 365 or office 2024 on a pc or mac. To show an answer and more information for … Find help with microsoft store purchases, subscriptions, refunds, payment options, and checking your order history. Find solutions to common problems, or get help from a support agent. Learn about the different reset options in windows and how to reset your device. Also non-genuine replacement displays may have compromised visual quality … Get microsoft billing support. Find out how to get support for microsoft apps and services. Log in to icloud to access your photos, mail, notes, documents and more. It includes the information you … Shop the latest apple products, including iphone, ipad, mac and more. If you need a replacement adapter to charge your apple device, we recommend getting an apple power adapter. Learn how to install office 2021, 2019, or 2016 on your pc or mac. Explore the innovative world of apple. Discover the innovative world of apple and shop everything iphone, ipad, apple watch, mac, and apple tv, plus explore accessories, entertainment, and expert device support. Learn how to sign in to office or microsoft 365 from a desktop application or your web browser. Visit now to experience expert device support. Search for help on the taskbar, use the tips app, select the get help link in the settings app, or go to support. microsoft. com/windows. Contact microsoft support. Sign in with your apple account or create a new account to start using apple services. Find how-to articles, videos, and training for microsoft copilot, microsoft 365, windows, surface, and more. This faq is intended to answer questions about upgrading a windows device to windows 11 from previous versions of windows such as windows 10. An apple account is the personal account you use to access apple services like the app store, icloud, messages, the apple online store, facetime, and more.
Astonishing Details: A Labeled Photomicrograph Of Bone!
Microsoft support is here to help you with microsoft products. Learn how to install, reinstall, or activate microsoft 365 or office 2024 on a pc...